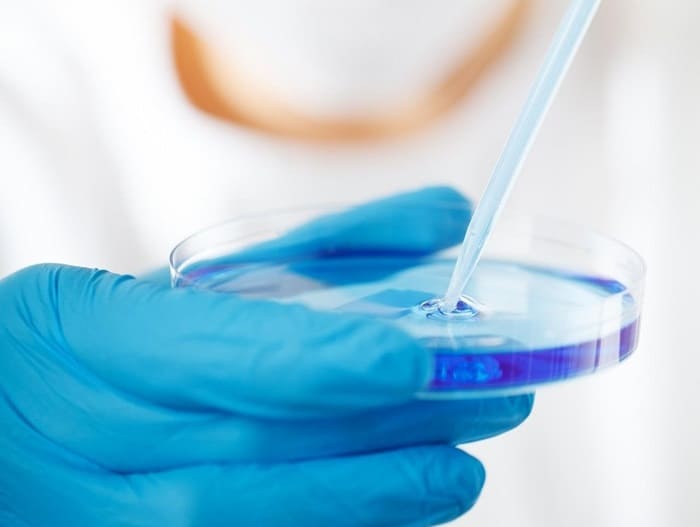
💧 Analisi #Legionella e nuovi obblighi

Con il #DecretoLegislativo182023 diventano obbligatori:
✅ Analisi periodiche
✅ Gestione del rischio
✅ Manutenzione impianti

👉agqlabs.it/2025/03/07/ana…

Proteggi la salute pubblica con AGQ Labs: analisi certificate e consulenza.

AGQ Labs
@agqlabs
International Testing Services and Consulting Laboratory Specialized in #Agriculture #Food #Environmental #Water #Services #Mining #Industrial & #Pharma sectors
ID: 487348179
http://agqlabs.com/ 09-02-2012 08:22:40
5,5K Tweet
1,1K Followers
790 Following